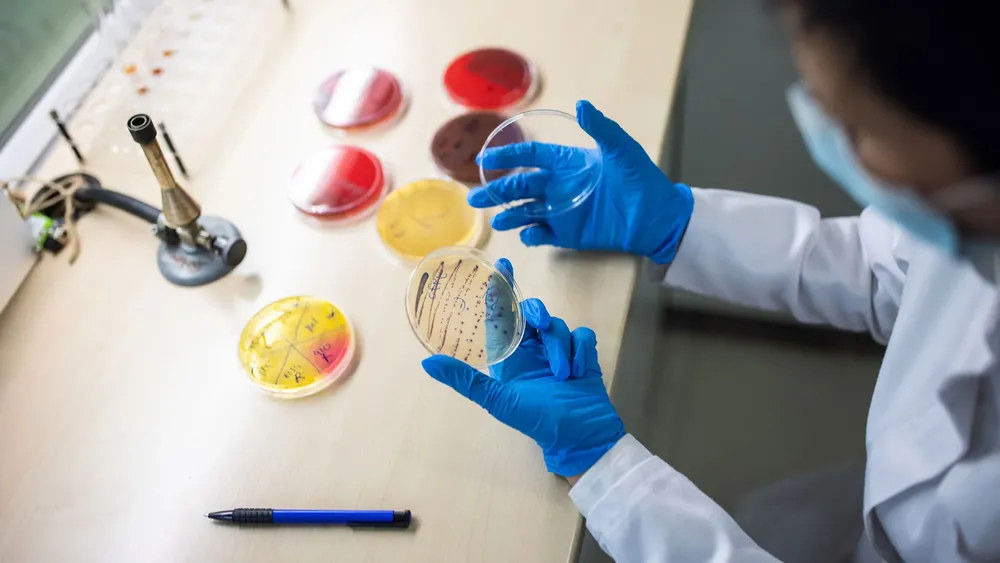
Síndrome Urémico 1

Santa Fe se suma a la prueba de un tratamiento para el síndrome urémico hemolítico
Se trata de una enfermedad grave en menores de 5 años, más frecuente en verano. Los ensayos serán en un nosocomio público y en otro privado
La provincia implementaba un sistema de avance continuo en la educación media, un plan similar al que se usa en los niveles universitarios y terciarios.
Provincia de Santa Fe12/12/2023 REDACCIÓN LMELos estudiantes secundarios de Santa Fe vuelven a enfrentarse a la posibilidad de repetir de año tras el decreto firmado este lunes por el gobernador Maximiliano Pullaro. De esta manera, el mandatario derogó el programa "escuelas secundarias de avance continuo", que pretendía disminuir la interrupción de las trayectorias educativas.

“Vamos a priorizar los aprendizajes; entendemos que para que eso suceda hay que poder evaluar a los chicos y que no sea todo lo mismo”, afirmó el mandatario santafesino ante la Asamblea Legislativa. Ponerle fin a este plan fue una de las primeras medidas del Gobernador.
Los estudiantes secundarios de Santa Fe vuelven a enfrentarse a la posibilidad de repetir de año tras el decreto firmado este lunes por el gobernador Maximiliano Pullaro. De esta manera, el mandatario derogó el programa "escuelas secundarias de avance continuo", que pretendía disminuir la interrupción de las trayectorias educativas.
En la misma línea, enfatizó que la cultura del esfuerzo "vuelve a ser prioridad" en el gobierno provincial. "La no repitencia era un atajo para mostrar que los chicos terminaban la escuela, cuando en realidad terminaban sin saber", dijo Pullaro.
"Significa que el chico que no aprenda, que no tenga los contenidos básicos, no pasará de año. Esto muestra el modelo que vamos a construir en educación y en toda la agenda de gobierno de nuestra provincia", auguró.
La disposición, ahora derogada, se aplicó en un puñado de escuelas secundarias de la provincia durante el 2023, aunque en realidad era parte de una política definida a nivel nacional.
¿Qué es la no repitencia?
La "escuela secundaria de avance continuo" era un proyecto del el Ministerio de Educación de Santa Fe que tenía como objetivo que los estudiantes avancen en sus estudios secundarios y solo recursen los espacios curriculares no aprobados.
En ese marco, las autoridades habían creado la figura de los docentes "acompañantes de trayectorias", quienes eran los responsables de acompañar ese proceso. Del proyecto participaron 145 escuelas, orientadas y técnicas, de gestión oficial y de gestión privada.
Uno de los aspectos más importantes de la iniciativa era que el hecho de adeudar materias no implicaba la interrupción de las trayectorias educativas. Además, las escuelas de avance continuo sumaron durante el último año una articulación "con el mundo del trabajo" y los estudios superiores.
Fuentes: https://www.pagina12.com.ar/694398-santa-fe-elimino-la-no-repitencia-en-las-escuelas-secundaria

Se trata de una enfermedad grave en menores de 5 años, más frecuente en verano. Los ensayos serán en un nosocomio público y en otro privado

Exigen la renovación de los contratos de diciembre y denuncian falta de personal en áreas sensibles, como enfermería.

Un informe elaborado por el Centro de Estudios Económicos y Sociales Scalabrini Ortiz (Ceso), a pedido del Sindicato Argentino de Docentes Privados (Sadop) Rosario, revela que desde diciembre de 2023 un maestro de grado con antigüedad mínima perdió 5,8 millones de pesos en términos reales.

La provincia de Santa Fe perdió 13.900 empleos privados registrados entre noviembre de 2023 y agosto de 2025

La tensión entre el gobierno de Santa Fe y las asociaciones de pescadores escaló este viernes luego de que se confirmara la suspensión de la reunión clave que se llevaría a cabo este lunes.

El Programa QUEDATE tiene como objetivo acompañar a las y los estudiantes en la continuidad de sus trayectorias educativas, brindando herramientas para reforzar aprendizajes y posibilitar la finalización del nivel secundario.

El secretario general de Amsafé, Rodrigo Alonso, cuestionó la decisión y advirtió un deterioro salarial en el año es del 7,7 %. También criticó que el incremento sea no remunerativo y que no se haya discutido en paritaria.

La Provincia confirmó que habrá una actualización salarial luego que la inflación de octubre alcanzó 2,7% y superó el aumento pautado en la paritaria

Un informe elaborado por el Centro de Estudios Económicos y Sociales Scalabrini Ortiz (Ceso), a pedido del Sindicato Argentino de Docentes Privados (Sadop) Rosario, revela que desde diciembre de 2023 un maestro de grado con antigüedad mínima perdió 5,8 millones de pesos en términos reales.
Se trata de una enfermedad grave en menores de 5 años, más frecuente en verano. Los ensayos serán en un nosocomio público y en otro privado

“Podemos colaborar, pero nosotros no aceptamos una intervención de ningún gobierno extranjero“, dijo la mandataria mexicana tras la amenaza de su par estadounidense.

Reclaman, entre otras cosas, “una jubilación mínima de $1.250.000 proporcional en todas las escalas, que respete la canasta básica total de la tercera edad”.

Analizan medidas de emergencia en Granja Tres Arroyos